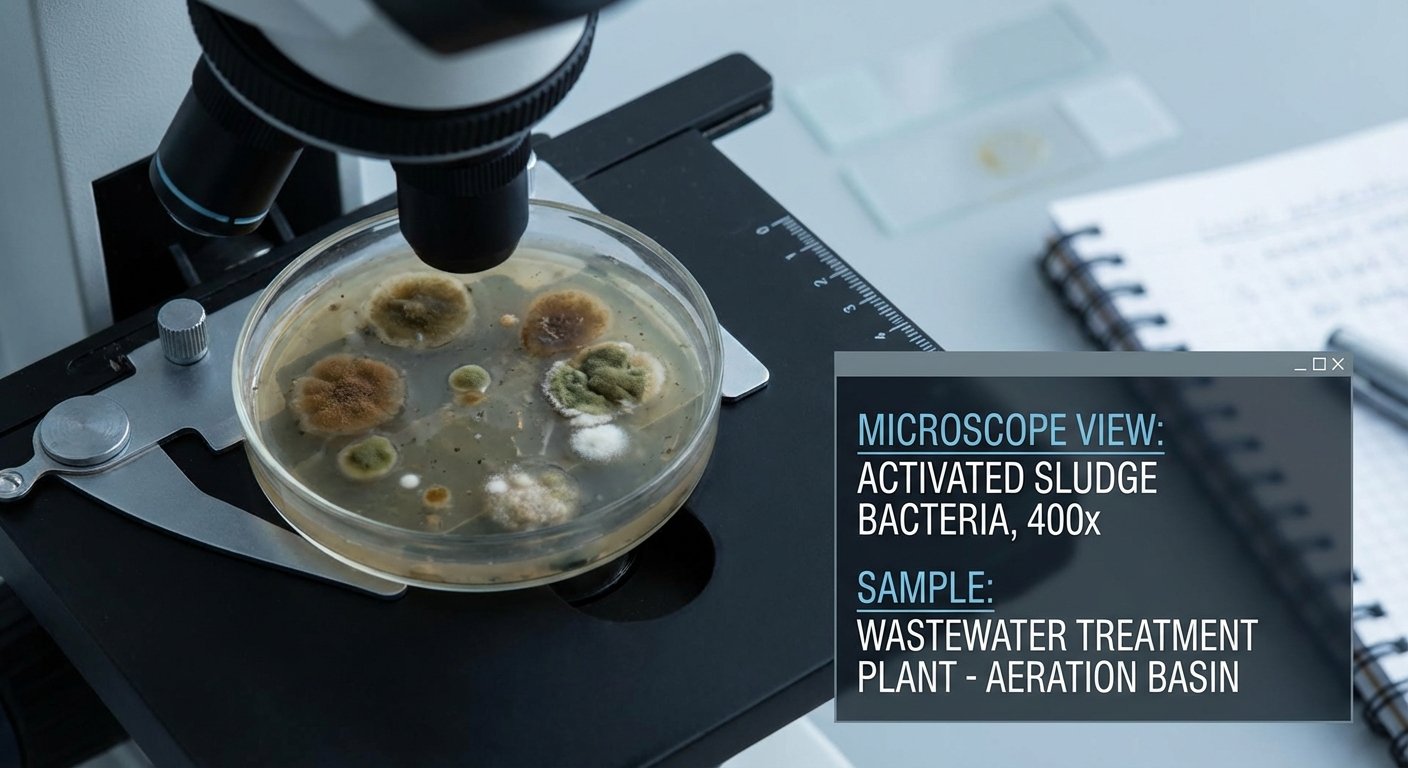
Baktēriju darbība notekūdeņu attīrīšanā

Baktērijas notekūdeņu attīrīšanas iekārtām ceļvedis
Pilns lietošanas ceļvedis par baktērijām notekūdeņu attīrīšanas iekārtām
Baktērijas notekūdeņu attīrīšanas iekārtām ir neatņemama sastāvdaļa, kas nodrošina efektīvu un videi draudzīgu atkritumūdeņu attīrīšanu.
Šajā ceļvedī mēs detalizēti aplūkosim, kāpēc baktērijas ir būtiskas, to dažādās sugas un lomas, kā arī sniegsim padomus piemērotāko baktēriju izvēlē un lietošanā. Uzzināsiet, kā risināt biežākās problēmas un uzturēt veselīgu mikrofloru jūsu notekūdeņu attīrīšanas sistēmā.
Neaizmirstiet apmeklēt SepticMix veikalu, kur atradīsiet kvalitatīvus baktēriju produktus jūsu iekārtai.
Kāpēc baktērijas ir būtiskas notekūdeņu attīrīšanā?
Baktērijas darbojas kā dabiskie bioloģiskie attīrīšanas aģenti, kas pārstrādā organiskos atkritumus notekūdeņos, padarot ūdeni tīrāku un drošāku videi. Tās samazina piesārņojuma slodzi un veicina attīrīšanas iekārtu efektivitāti, nodrošinot ilgtspējīgu darbību bez ķīmisku vielu pārmērīgas izmantošanas.
- Dabiskā organisko vielu sadalīšana un pārstrāde
- Efektīva piesārņojuma un toksīnu samazināšana
- Uzlabota ūdens kvalitāte un ekoloģiskā līdzsvara uzturēšana
- Samazina nepatīkamo smaku rašanos sistēmā


Galvenie baktēriju veidi un to funkcijas sistēmā
Notekūdeņu attīrīšanas sistēmās darbojas dažādi baktēriju veidi, katram no tiem ir specifiska loma attīrīšanas procesā. Saprotot to funkcijas, var optimizēt sistēmu darbību un sasniegt labākus rezultātus.
- Aerobās baktērijas: plaukst skābekļa klātbūtnē, sadalot organiskās vielas un samazinot piesārņojuma līmeni.
- Anaerobās baktērijas: darbojas bez skābekļa, sadalot sarežģītākas organiskās vielas un radot mazāk blakusproduktu.
- Fakultatīvās baktērijas: pielāgojas gan aerobiem, gan anaerobiem apstākļiem, nodrošinot elastīgu attīrīšanu dažādos posmos.
- Kombinācija nodrošina pilnīgu un efektīvu piesārņojuma biodegradāciju.

Aerobās baktērijas un to loma
Aerobās baktērijas ir primārais attīrīšanas elements, kas sadala organisko vielu un palīdz uzturēt sistēmas līdzsvaru.
- Prasīgas pret skābekļa pieejamību
- Efektīvi pārstrādā piesārņojumu vieglākā formā

Anaerobās baktērijas un to uzdevumi
Anaerobās baktērijas izjauc smagos organiskos savienojumus bez skābekļa, nodrošinot ilgstošu attīrīšanu.
- Strādā bez skābekļa pieejas
- Samazina bioloģisko atkritumu apjomu

Fakultatīvās baktērijas kā starpposms
Šīs baktērijas pielāgojas dažādiem apstākļiem, nodrošinot sistēmas stabilitāti un attīrīšanas procesa pabeigšanu.
- Pielāgojas gan ar, gan bez skābekļa
- Uztur aktīvu mikrofloru dažādos posmos

Kā izvēlēties piemērotākās baktērijas savai iekārtai?
Izvēle jābalsta uz iekārtas tipu, slodzi un enerģijas resursiem, lai nodrošinātu optimālu baktēriju darbību.
- Iekārtas tipa un noslodzes novērtējums
- Starta kultūru un uzturošo līdzekļu izvēle
- Produktu formu salīdzināšana (pulveris, šķidrums, tabletes)
Kā izvēlēties piemērotākās baktērijas savai iekārtai?
Lai nodrošinātu maksimālu efektivitāti, ir svarīgi izvērtēt jūsu notekūdeņu attīrīšanas iekārtas īpašības un vajadzības. Tas palīdzēs izvēlēties pareizo baktēriju maisījumu un formu, kas vislabāk atbilst jūsu apstākļiem.
- Iekārtas tipa un slodzes novērtēšana: Ņemiet vērā iekārtas tilpumu, darbības režīmu un atkritumu daudzumu.
- Starta kultūru un uzturošo līdzekļu izvēle: Jūs varat izvēlēties efektīvas baktēriju kultūras, kas palīdz iesākt vai uzturēt nepieciešamo mikrofloru.
- Produktu formas salīdzinājums: Pulveri, šķidrumi un tabletes ir dažādas formas, katrai ir savas priekšrocības lietošanā un uzglabāšanā.
Apskatiet plašu produktu klāstu mūsu veikalā un saņemiet profesionālu konsultāciju, lai atrastu sev piemērotāko risinājumu.


Soli pa solim instrukcija pareizai baktēriju lietošanai
Lai nodrošinātu baktēriju maksimālu efektivitāti, svarīgi ievērot pareizu lietošanas kārtību un regulāru iekārtas apkopi.
- Sākotnējā deva – ievadiet starta baktērijas atbilstoši ražotāja instrukcijai.
- Regulāra papildināšana – uzturiet baktēriju aktivitāti ar periodisku devu lietošanu.
- Pareiza iekārtas temperatūra un skābekļa pieejamība – nodrošiniet optimālus apstākļus baktēriju darbībai.
- Izvairīšanās no kaitīgām ķimikālijām, kas var likvidēt mikroorganismus.
Šī rūpība garantēs ilgtspējīgu un efektīvu notekūdeņu attīrīšanu jūsu sistēmā.
Kā novērst nepatīkamas smakas?
Negatīvas smakas bieži rodas baktēriju līdzsvara trūkuma dēļ.
- Uzturiet optimālu baktēriju populāciju
- Izmantojiet specifiskus baktēriju maisījumus smaku novēršanai

Ko darīt tauku un nosēdumu gadījumā?
Tauki un nosēdumi var aizsprostot iekārtas un samazināt efektivitāti.
- Izmantojiet taukus šķeļošas baktērijas
- Regulāri veiciet iekārtas uzturēšanu ar piemērotiem līdzekļiem

Sistēmas darbības atjaunošana pēc pārtraukuma
Pēc ilgāka pārtraukuma nepieciešama mikrofloras atjaunošana.
- Ieviest starta kultūras saskaņā ar ražotāja ieteikumiem
- Uzraudzīt mikroorganismu aktivitāti un pielāgot uzturu

Kā uzturēt veselīgu mikrofloru attīrīšanas iekārtā ikdienā?
Ikdienas rūpes par mikrofloru ir izšķirošas ilgstošai un efektīvai notekūdeņu attīrīšanai.
- Regulāra produktu lietošana atbilstoši iekārtas vajadzībām
- Temperatūras un skābekļa līmeņa kontrole
- Izvairīšanās no kaitīgām ķīmiskām vielām un pārslodzēm
Kopsavilkums par baktēriju nozīmi notekūdeņu attīrīšanā
Baktērijas notekūdeņu attīrīšanas iekārtām ir neaizvietojams elements, kas nodrošina dabīgu un efektīvu piesārņojuma pārstrādi. Pareiza baktēriju izvēle, lietošana un sistēmas uzturēšana garantē tīru vidi un ilgtspējīgu iekārtu darbību.
Apsveriet iespēju sazināties ar speciālistiem šeit, lai saņemtu personalizētus ieteikumus un atbalstu.
DUK
Kāpēc baktērijas ir tik svarīgas notekūdeņu attīrīšanā?
Tās dabiski sadala organiskos atkritumus un samazina piesārņojumu, padarot ūdeni tīrāku un drošāku.
Kā noteikt, kuras baktērijas attīrīšanas iekārtai izvēlēties?
Jāizvērtē iekārtas tips, slodze un darbības apstākļi, kā arī jāizvēlas piemēroti produkti ar atbilstošu baktēriju kombināciju.
Kā uzturēt baktēriju aktivitāti ilgtermiņā?
Nodrošiniet regulāru produktu lietošanu, optimālus temperatūras un skābekļa apstākļus, izvairieties no ķīmiskajiem piesārņotājiem.
Plašāka informācija par notekūdeņu attīrīšanu pieejama arī Wikipedia.


